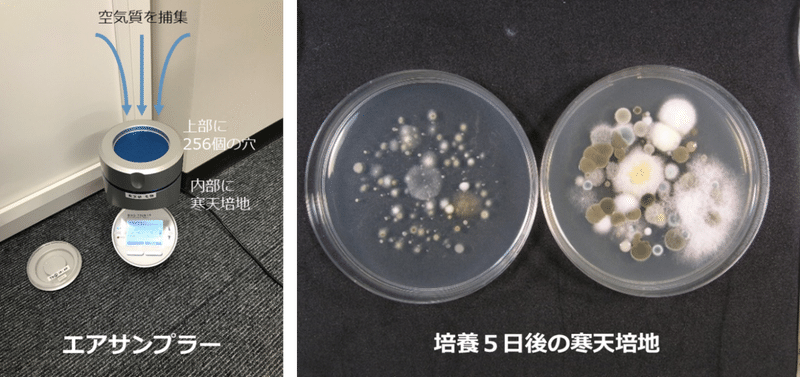

大腸菌コロニーからの PCR Blend Taq® Quick Taq® HS DyeMix →P10 酵母・カビコロニーからの PCR KOD FXシリーズ →P10 植物ライセートからの PCR KOD FXシリーズ →P11 土壌ライセートからの PCR KOD FXシリーズ →P8糸体( mycelium)又はコロニーとよんでいる。 その繊維状の構造と葉緑素を全く持っていな いことから研究者の人達はカビを植物として 扱わず、むしろ菌類のカテゴリーにあてはめ て研究することが多い。 上記したようにカビは胞子によって繁殖、カビに関する研究 Ⅰ 概要 私たちの研究は空気中のカビを寒天培地で培養する研究である。培養させたカビに 身近な化学物質を加えたり、pH の異なる培地で培養させたりなどして、カビの生育状 況を調べた。 Ⅱ 研究目的・意義

おそうじ本舗 浴室の 防カビコート 開発 くらしスタイル研究所
カビ コロニー 形状
カビ コロニー 形状-カビのコロニーが観察されない菌床表面部分で も,全てのサンプルからカビが検出されました。 菌床1からトリコデルマ2種類,クラドスポリウ ム(クロカビ)1種類(イラスト7),および分 生子(胞子)の無い糸状菌1種類,菌床2からトカビとカビ毒 わが国は、カビの発育に適した気候条件のため、昔からみそや醤油などの製造を通してカビに 親しんできた歴史があります。 しかし、その一方で、東京都の保健所には、カビによる食品の苦情が多く寄せられています。


10日間使用した毛布は細菌とカビが大量に繁殖 白い球状のものは細菌の集落 コロニー で1個約10万匹位 ぼやけた大きく薄い集落はカビ 服部 サッとスプレーしながら10日間使用した毛布 にはカビが生えず 菌もわずかになりました
青緑色のコロニーを酵母として計測します。 カビ数 = 45 カビは多彩な色調で出現することがあります。 酵母数 = 6、カビ数 = 44 酵母数 = 16、カビ数 = 43 酵母数 = 45 食品残渣の形状は不定形です。フォームダムの外に生育しているコロニーは カウントしません。カビが作る毒性物質によって起きるカビ中毒(食中毒) まず、 クロカビはカビ毒を作りません のでご安心ください。 ただし、クロカビを食べても大丈夫という意味ではありません。カビと臨床検査 を培養し、培地にジャイアントコロニー(巨大で単一の菌塊)を発育させる事で、その発育速度や色(裏表)、 コロニー表面の状態、菌糸の状態などを観察します。一般細菌の多くは24時間程度で発育しますが、糸状菌は数週間かかる
カビコロニー コロニーカウント 培地色・気泡 蛍光 細菌用培地,真菌用 培地に、試料(液)を一 定量接種し、培養後の 集落(コロニー)を観察・ 計数する。 計数値:個/mL 液体培地に試料(液)を一定量入れ、培養 後の液色の変化・気泡の有無、蛍光の有カビが生えやすい環境 カビとは カビとは、真菌類に属しています。 同じ仲間には、酵母やキノコがあります。 1mm以下の肉眼では見ることのできない、微生物の集落(コロニー)の俗称でもあります。 カビの生えやすい場所 カビには生えやすい場所がQ8.カビ発生原因別対策 結露が原因であった場合 (冷たい壁面や窓) 1)結露を拭き取ります。 2)通気性をよくします。 3)除湿度をします。 4)部屋と結露面の温度差を減らします(例として断熱処理等)。 大量の水蒸気が原因の場合(浴室など) 1)発生した水蒸気を外に出します。 2)壁面の水滴を拭き取ります。
概 要 カビの帰属種・近縁種を同定する際、当社がお薦めする試験セットです。 「DNA塩基配列解析 (考察付) 」と「形態観察」などの性状試験を組合わせますので、遺伝子解析単独での試験よりもより深い考察が可能となります。 学会発表や特許取得などの研究や製品開発など、微生物株についてより詳細な情報を必要とするお客様に有効となり、近縁種の推定とカビと細菌は全く別物~細菌は単細胞、カビは多細胞! まずカビと細菌では歴史が違います。 細菌が地球上に現れたのは約40億年前、カビは約10億年前と言われており、生物としては細菌の方が大先輩です。 細菌のような原始的な生物から30億年かけて進化した先にカビがあると考えれば、細胞の基本構造から増殖方法に至るまで、両者の生物としての有り様が細菌コロニーと真菌コロニーの違い の 主な違い バクテリアと菌類のコロニーの間に バクテリアのコロニーは明確なマージンを持つ小さい、滑らかな、または粗いコロニーですが、真菌のコロニーはあいまいな外観を持つ大きいコロニーです。 。 さらに、細菌コロニーは湿って光沢があるように見えますが、真菌コロニーは粉末状です。 細菌および真菌コロニー



寒天版のカビと細菌のコロニー の写真素材 画像素材 Image



メイクツール しっかりケアしてる 放っておくと雑菌が 正しいケアの頻度や方法をプロが解説 美的 Com
に住んでいるカビの社会にもおのずと変化が認 められる(図3).これから,乾性を好むカビと 適潤性を好むカビがあることがわかる.またそ うした変化になんの影響もうけない種類もみら れる. ④カビの重要性 土の中の有機物の分解で,カビの類がどの一般のアオカビと同様に緑色のコロニーを形成す るため,見掛け上は壁画の黒色スポットとは無関 係のようであるが,長期間の培養で次第に黒変し, 正しく黒色スポットの主要な原因菌と分かった。 石室内の湿度は95~100%,温度は15~19℃検出可能な菌:真菌(カビ・酵母) 培 養 条 件:25℃ 2 日~7 日間 判 定:全ての生育したコロニー 特 徴:本培地はカビおよび酵母の検出培地です。 真菌は土中や空気中に存在し、検体の表面に付着し



この菌は何ですか Okwave


マイクロバイオ検査システム 応用例
白カビ・青カビ・赤カビ・黒カビの違い! 毒性の強さと生えやすい場所 18年9月26日 年3月27日 掃除・洗濯 梅雨などのジメジメした季節に目にすることの多い カビ 。 現在8万種類以上のカビが確認されていて、ゆくゆくは万種類以上になるともいわれている存在です。 カビの色には「白」「青」「赤」「黒」など様々なものがありますが、どのような違いが真菌(カビ) 大きさ 基本的な構造 人への感染 ウイルスは単独では増殖できないので、人の細胞の中に侵入し増殖する 体内で定着して細胞分裂で自己増殖しながら、人の細胞に侵入するか、毒素を出して細胞を傷害する 人の細胞に定着し、菌糸が成長と分枝(枝分かれ)によって発育していく 酵母細胞では出芽や分裂によって増殖するカビの生育を阻止した円の有無,発生したカビのコロニーの個数 研究の結果 まずは、フン抽出液を染み込ませたペーパーディスクを置くと同時に、被検菌 液を噴霧する手順で 実験1 防カビ物質は界面活性剤Tween80 で可溶化できるか。



細菌やカビのコロニーとシャーレ の写真素材 画像素材 Image



セキスイハイムの天井裏でカビ繁殖 セキスイハイム で注文住宅
より安全な方法(特許工法)でカビ退治をします。 酵母は、健康被害の例はあまり聞きません。 酵母の細胞は径が3㎛~5㎛前後で球形、卵形、楕円形が普通です。 出芽増殖を行ない、コロニー(かたまり集合体)をつくり、ポツポツと丸く球状に見えます。カビ 第一段階試験 ・巨視的観察として、コロニーの直径、色調 (コロニー表面・裏面) 、 表面性状、可溶性色素産生の有無など ・微視的観察として栄養菌糸、無性生殖器官、有性生殖器官など ・考察文章(同定に至った経緯の文章説明)+ 同定結果 カビ 第二段階試験 ・巨視的観察として、コロニーの直径、色調 (コロニー表面・裏面) 、 表面性状、可溶性色素生育して来たコロニーが細菌のものか,カ ビのものか の区別は,コ ロニーの所見で簡単に出来る。細菌のコロ ニーは湿潤で光沢があり,一定の大きさより大きくなら ない。それに反しカビのコロニーは培地表面より上に伸 びながら巨大コロニーに発育する。


10日間使用した毛布は細菌とカビが大量に繁殖 白い球状のものは細菌の集落 コロニー で1個約10万匹位 ぼやけた大きく薄い集落はカビ 服部 サッとスプレーしながら10日間使用した毛布 にはカビが生えず 菌もわずかになりました


ペニシリンの偶然の発見
コロニーの縁が不明確である。 淡赤褐色から青緑の色調 多彩な色(カビ自身が色素を産生することもある) コロニーが盛り上がっている。 扁平なコロニー 通常コロニーの中心に芯(色の濃い中心点)が見られない。 通常コロニーの中心に芯見られる。アカカビ (フザリウム) 生育が早い。 コロニーは羊毛状、白色、黄色、褐色、ピンク色、赤橙色、赤紫色など菌の種類により様々。 色素を溶出する種類もある。 植物や河川、工場廃水、土壌などに多く、プラスチックにもつく。★ カビと酵母の簡単な見分け方 ★ 1臭いを嗅いでみましょう。 カビ臭がすればカビ、しなければ酵母です。 2大きさを見ましょう。 黒くベターッと広がっていればカビ、赤や黄色の1㎜程度の点々が飛んでいる状態なら酵母です。


194黒砂糖のカビ2


カビの写真07



真菌用 サブロー寒天培地 Cp加サブロー寒天培地 株式会社アテクト


Article



日水製薬 コスモ会 コスモ会質問箱 Q A


検査室タイムズ Tekari 臨床検査技術部



カビと放線菌 Dr Tairaのブログ



住宅環境中のカビ 研究員オダの環境レポート



カビ形態観察 株式会社テクノスルガ ラボ



家族の健康をおびやかすカビの正体を探れ ハウスクリーニングならサニクリーン 全国対応



やるかやられるか 菌たちの戦いの最前線 株式会社ビッグバイオ



細菌やカビのコロニーとシャーレ の写真素材 画像素材 Image



カビ対策マニュアル 基礎編 文部科学省



Botrytis Cinerea 灰色かび病菌 灰色カビ病菌 コロニー 培地 子嚢菌 10日培養の写真素材



ペトリ皿に繁殖するカビや細菌を フェルトや刺繍などの手芸で表現 新たなる小宇宙が生まれたようだ カラパイア



バイオカフェレポート カビってこんなに面白い


10日間使用した毛布は細菌とカビが大量に繁殖 白い球状のものは細菌の集落 コロニー で1個約10万匹位 ぼやけた大きく薄い集落はカビ 服部 サッとスプレーしながら10日間使用した毛布 にはカビが生えず 菌もわずかになりました


245砂糖結晶に生えたカビ


Ufocrroxcr8aem


検査室タイムズ Tekari 臨床検査技術部



同定を目的とした培養平板について 株式会社テクノスルガ ラボ



おそうじ本舗 浴室の 防カビコート 開発 くらしスタイル研究所


検査室タイムズ Tekari 臨床検査技術部



カビ調査 Amenity Technology Co Ltd



透明な背景に分離型カビ菌のコロニー斑点の写実的な画像と編集可能なテキストベクターイラストのセット のベクター画像素材 ロイヤリティフリー



カビとは カビの基本 カビをやっつけるにはooが有効 ネットdeカガク


カビの美しい実験室の微生物学からの培養培地プレートに真菌 の特性のコロニー うどん粉菌のストックフォトや画像を多数ご用意 Istock


カビのコロニーとシャーレ イラストレーションのベクターアート素材や画像を多数ご用意 Istock



洗濯機に生えるカビ クラドスポリウムが少ない カビを除去するコツ Ipm研究室 エフシージー総合研究所



菌種から探す 株式会社アテクト



カビ Dragonfruits25のブログ



菌糸 Wikipedia



カビ Wikipedia



カビとは どんな種類がある 生える原因は湿度や温度が高いから コジカジ


食品ネット分析室


カビの写真05



チーズ A To Z 3月 17


くらし科学研究所 カビ に対する殺菌剤の効果に関する調査


カビとは何 耐久性防カビ方法を用いた防カビ専門業 カビ屋 検索サイト 防カビ Net



正体はコレ 細胞培養でのコンタミの原因と対策 Learning At The Bench



正体はコレ 細胞培養でのコンタミの原因と対策 Learning At The Bench



カビ対策マニュアル 基礎編 文部科学省



カビの色を写真で紹介 黒色以外にもオレンジのカビ 黄色のカビ 緑のカビなどカラフル カビトリ



エアコン洗浄サービス メンテナンスサービス ダイキン工業株式会社



細菌やカビのコロニーとシャーレ の写真素材 画像素材 Image



お役立ち情報 まさか漆喰の壁にカビが そんな時どうすれば 連載コラム その8 株式会社サンオリエント



Botrytis Cinerea 灰色かび病菌 灰色カビ病菌 コロニー 培地 子嚢菌 14日培養の写真素材



微に入り細に入り 和食文化の立役者はコウジカビ 2 2ページ 産経ニュース



業界初プラズマクラスター技術がカビの生育ステージ別に抑制効果を発揮することを実証 プラズマクラスター技術 シャープ


検査部 検査室紹介



共同発表 カビが伸びて成長する仕組みを超解像顕微鏡で解明



楽天市場 バイオチェッカー 真菌 カビ 酵母 測定用 M 1箱 10本入 Pro Lab Healthcare Shop



シャーレ上の室内空気からサブーラード デキストロース寒天で栽培されるオルタナリアカビのコロニー の写真素材 今すぐ編集


ラーメン スープ工場内から検出される カビ



真菌 カビ 酵母 と微生物検査 完結 食品の品質デザイナーをブランドに



17 号 カビの生死判定方法及びカビの生死判定装置 Astamuse

空間の 汚れ の実態 アフターコロナの施設清掃


食品ネット分析室



カビの種類 カビの種類は よく見かけるあのカビはどんな特徴 Limia リミア



同定を目的とした培養平板について 株式会社テクノスルガ ラボ


カビと酵母の違いを知っていますか Soken社長ブログ 社長の独り言 クロスのカビやヤニ取りなどの掃除や除去 洗浄なら創研へ


検査室タイムズ Tekari 臨床検査技術部



早川昌志 ミクロ ライフpj V Twitter カビや酵母 バクテリアのコロニーのできかた 2 複数箇所でコロニーが成長していって コロニー同士が出会うと うまいこと境界ができる ちょっとした芸術 おもしろい


くらし科学研究所 内部まで侵入したカビの殺菌方法に関する調査


カビ観察 続報21日目 大きな変化 カビ対策や細菌 ウイルス 悪臭などから守る 潔癖症の健康生活



3mtm Petrifilmtm Rapid Yeast And Mold Count Plate Manualzz


異なる細菌やカビのコロニー アレルギーのストックフォトや画像を多数ご用意 Istock



食品微生物検査の手順 一般生菌数 Sanifoods サニーフーズ 特集 Axel アズワン Axelショップ



カビ調査の流れ カビ 環境リサーチ株式会社 アスベスト シックハウス 騒音振動 環境の総合コンサルタント



カビは目で見えない場所でも生えているって本当 カビの除菌方法は カビペディア カビの悩みならカビペディア



楽天市場 植木鉢カビ対策 ガードマーブル0 2袋セット内容量230gx2植木鉢の土表面のカビをガード 自然の大理石は室内植木鉢の化粧にもなります 抗菌防カビ剤は特許技術成分による人に無害製品です 5号鉢用 製造元正規品 単品発送はメール便の為代引き時間指定


標準寒天培地の赤いコロニー


カビの生理活性調整剤およびその利用方法



10 号 カビの生理活性調整剤およびその利用方法 Astamuse



実施例 バイオ事業総括部 バイオプロダクト営業部



カビ原因調査 Amenity Technology Co Ltd


メリー クリソゲヌム 総天然色のカビが作るモコふわアート


Article



猪口 雅彦 ついでに部屋の清浄度のチェックのために 同じ微生物用培地を5分間ほど室内で蓋を外して放置してみたのですが こちらも カビのコロニーが1個出来ただけでした 案外きれい ゚ ゚ というわけで 植物組織培養はご家庭でも十分可能です



業界初プラズマクラスター技術がカビの生育ステージ別に抑制効果を発揮することを実証 ニュースリリース シャープ



カビ 細菌コロニーの上面図が背景に分離されたベクトルペトリ皿 無料のベクター



続 微生物の数え方 株式会社衛生微生物研究センター



日水製薬 コスモ会 コスモ会質問箱 Q A



この時期の飼料の注意 有限会社シェパード中央家畜診療所
0 件のコメント:
コメントを投稿